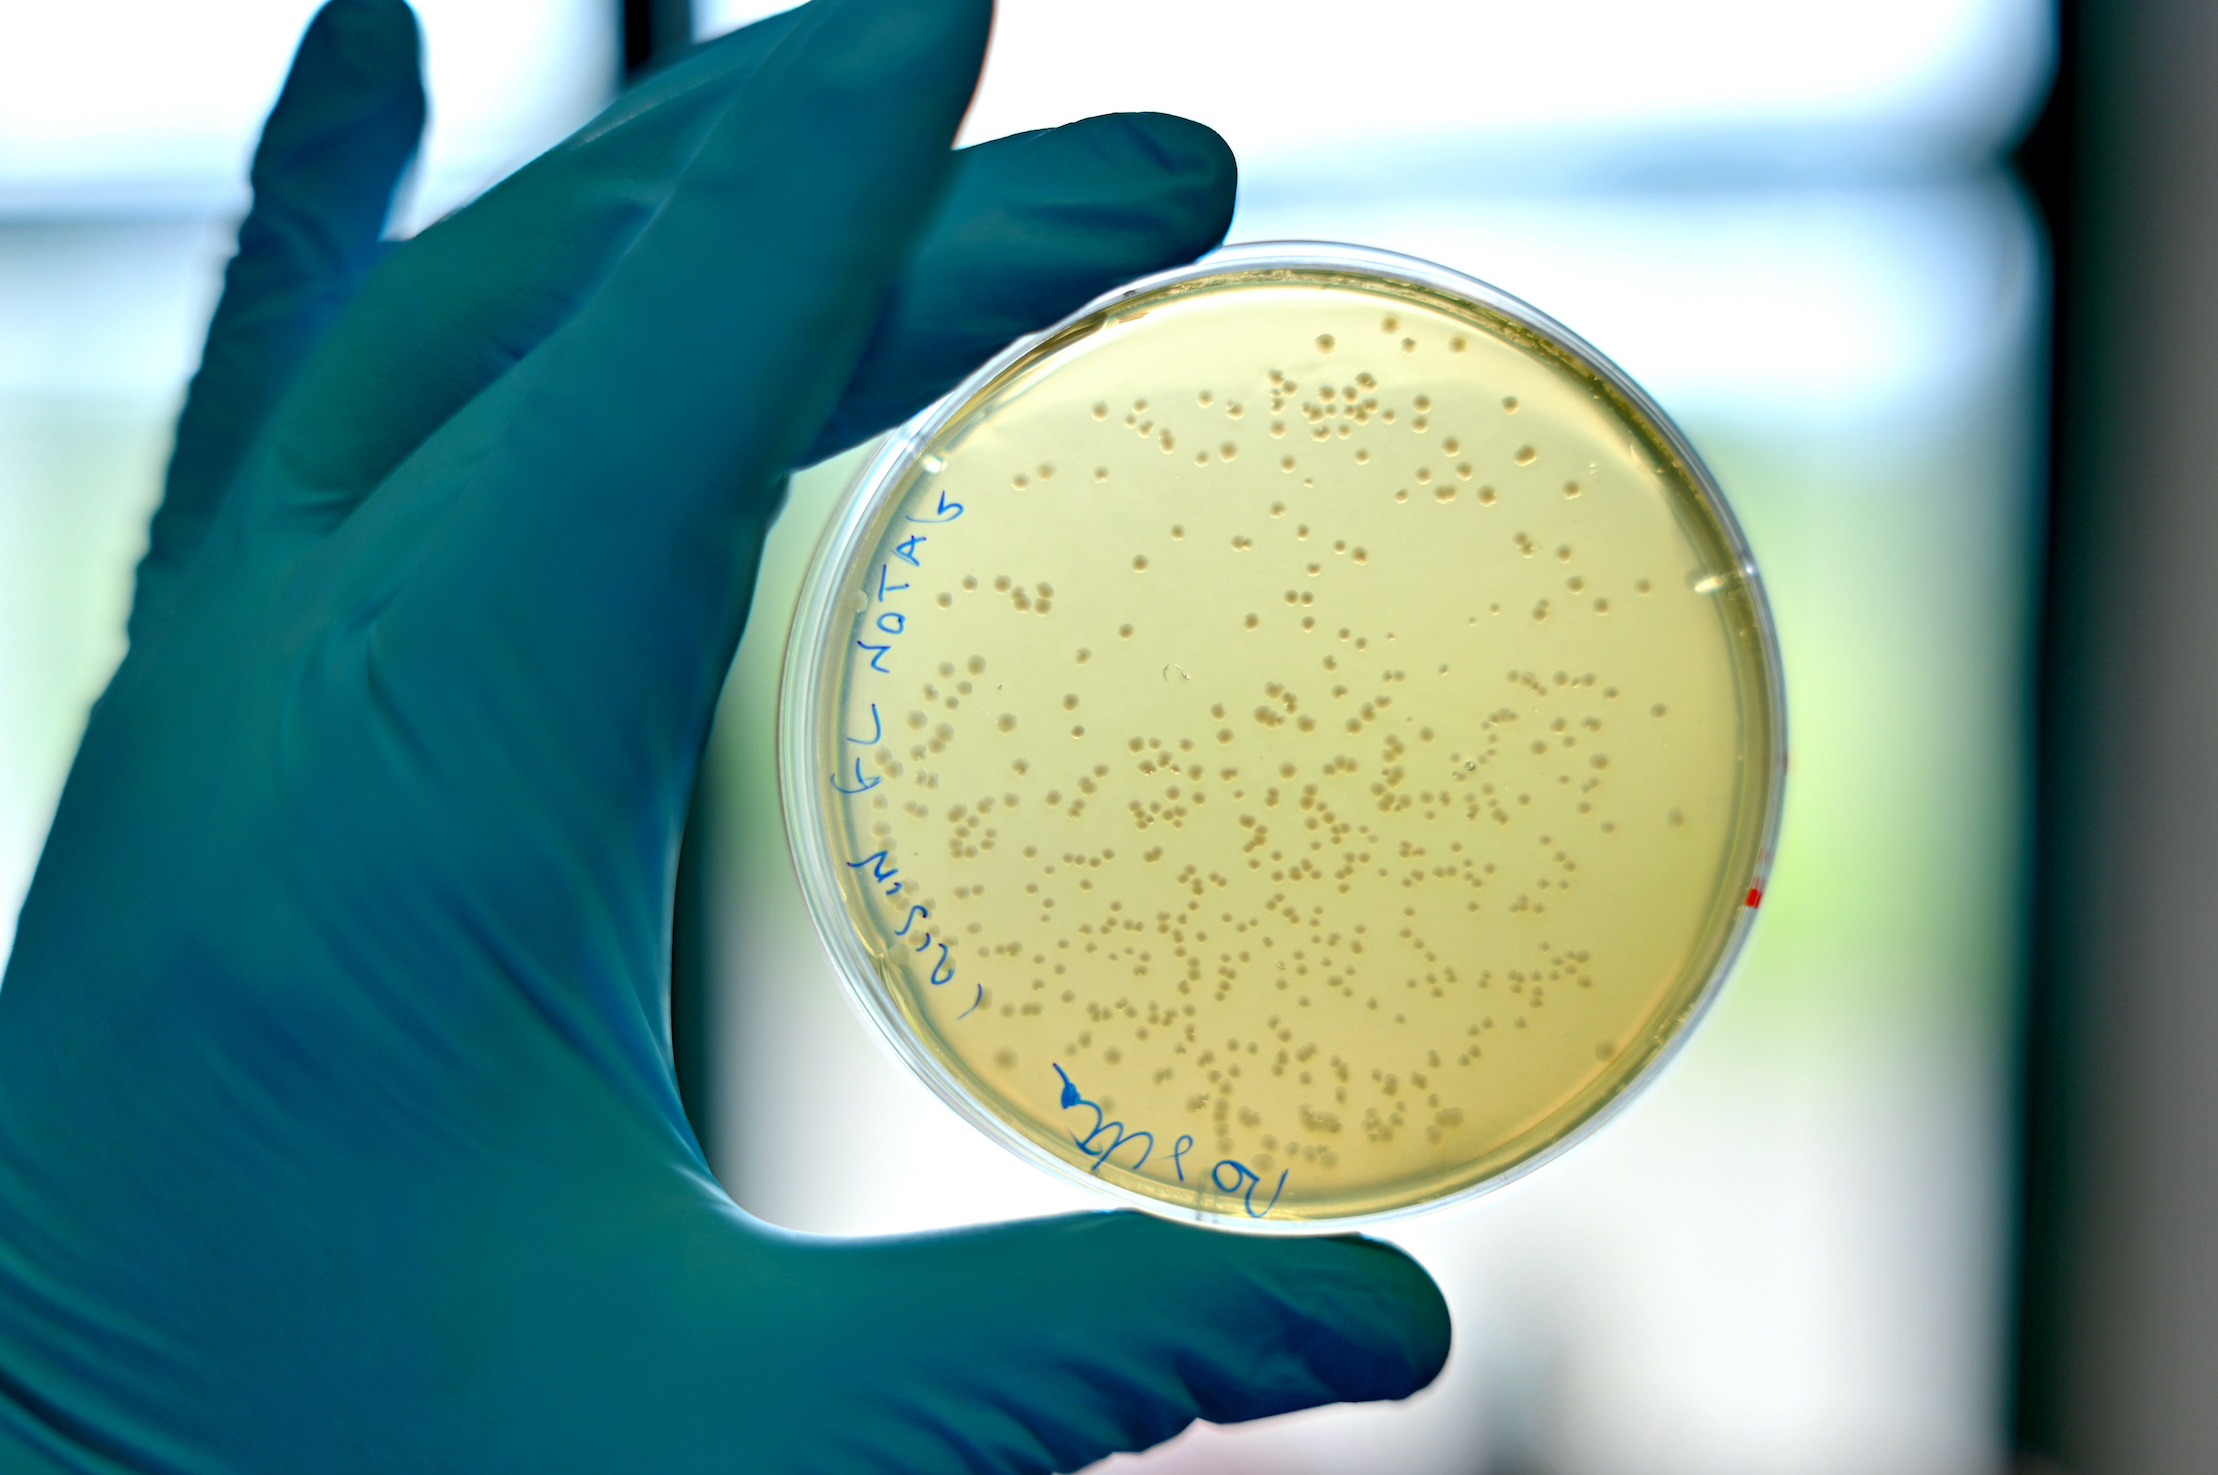
Image

UNITA’ DI PRODUZIONE DI PROTEINE E ANTICORPI
Group Leader: Alessandra Fucci (PhD)
Senior advisor: Maria Luisa Nolli (PhD)
Staff: Assunta Riccio (PhD)
Egildo Luca D’Andrea (PhD)
Simona Giacobbe (PhD)
Ylenia Abruzzese (BSc)
Le attività includono anche: messa a punto e validazione di test immunoenzimatici; analisi dell’affinità e di cinetica di legame mediante SPR; sviluppo di protocolli per l’industrializzazione dei processi di produzione di biosimilari; produzione di enzimi ricombinanti.
L’Unità dispone di molteplici ceppi e linee cellulari ed ha una vasta libreria di vettori di espressione, da impiegare nei processi produttivi di proteine e anticorpi.
L’utilizzo di strumenti e di tecnologie all’avanguardia e l’impiego di strategie su misura, disegnate ad hoc per ciascun progetto, consentono di operare ad alta efficienza e con un elevato grado di successo. Infine, l’accesso a metodi analitici avanzati, che includono SPR, HPLC e LC-MS/MS, consente di effettuare una caratterizzazione completa delle biomolecole prodotte.
Principali servizi offerti
- Sintesi genica, ottimizzazione dei codoni e generazione di vettori di espressione
- Test di espressione in E. coli, P. pastoris o Mammalian cells
- Ottimizzazione dell’espressione e messa a punto dei protocolli di purificazione
- Scale-up della produzione
- Analisi di quantità, purezza ed integrità (UV-Vis, SDS-PAGE, HPLC e Western Blot)
- Caratterizzazione biochimica (HPLC, LC-MS/MS) e studi di affinità (SPR)
- Dosaggio e rimozione dell’endotossina
- Marcatura/coniugazione
Sviluppo di anticorpi monoclonali e policlonali
- Definizione delle strategie di immunizzazione
- Design e produzione dell’antigene (opzionale)
- Immunizzazione (topi, ratti o conigli) ed esecuzione dei test di titolazione
- Generazione e screening di ibridomi (solo per la produzione di mAb)
- Stabilizzazione e banking degli ibridomi
- Purificazione degli anticorpi (0.1-100 mg)
- Caratterizzazione degli anticorpi (isotipizzazione, SDS-PAGE, ELISA, HPLC, SPR)
Sviluppo di saggi immunoenzimatici
- Selezione e pairing degli anticorpi
- Generazione della calibration curve per applicazioni quantitative
- Ottimizzazione, qualifica e validazione del saggio in diverse matrici
- Produzione e fornitura di kit custom
- Adeguamento di metodi ELISA già esistenti per l’uso in nuove applicazioni.
Ricerca Biotecnologica